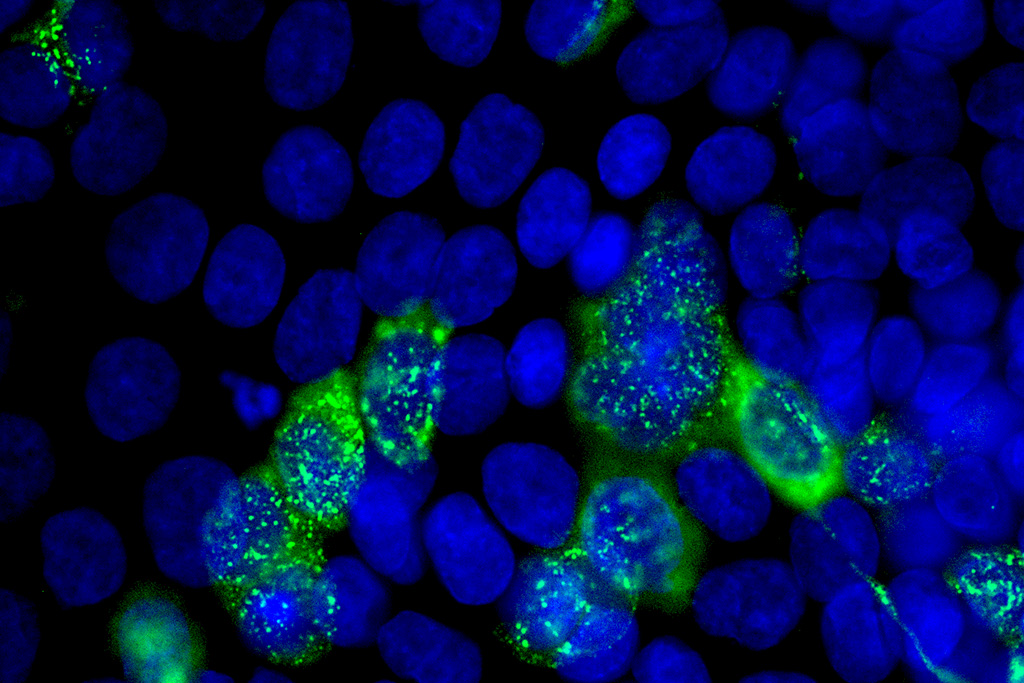

También contra coronavirus
Un grupo de investigación mostró que el Imiquimod, un fármaco que se utiliza para tratar las verrugas genitales provocadas por el virus del papiloma humano (HPV), inhibe la replicación del SARS-CoV-2 y del coronavirus canino. Ya habían demostrado que también actúa sobre el virus sincicial respiratorio, responsable de la bronquiolitis.
Ante la posible emergencia de nuevos virus e, incluso, de una nueva pandemia, contar con antivirales de amplio espectro que puedan aplicarse sin saber de antemano de qué virus se trata podría ser algo muy beneficioso.
Asimismo, como los antivirales de amplio espectro no suelen actuar directamente sobre el virus sino sobre algún sitio del huésped que el virus necesita para prosperar, también suelen presentar la ventaja de esquivar el problema que significa que un virus pueda mutar.
En el Laboratorio de Virología (LV) de la Facultad de Ciencias Exactas y Naturales de la UBA han demostrado la actividad antiviral de amplio espectro de varias sustancias. Una de ellas fue VIREST, que mereció el premio mayor del concurso INNOVAR en 2014. También, en colaboración con el Laboratorio de Estrategias Antivirales, mostraron que el cannabidiol, uno de los principios activos de la planta de marihuana, inhibe la replicación de diferentes tipos de virus. Lo mismo demostraron con un compuesto presente en el extracto de la semilla del castaño de Indias.
El grupo pudo demostrar la actividad antiviral del Imiquimod contra el SARS-CoV-2 en cultivos celulares. Ahora quieren estudiarlo en animales.
De igual manera, en 2020 publicaron un trabajo en el que revelaban que el Imiquimod -un medicamento que se usa en forma de crema para tratar las verrugas genitales provocadas por el virus del papiloma humano (HPV) y ciertos tipos de lesiones malignas de la piel- inhibe la replicación del virus sincicial respiratorio, responsable de la bronquiolitis.
Se sabía entonces que el Imiquimod tenía actividad antiviral contra el virus herpes simple y que podía prevenir la infección por el virus influenza, el que provoca la gripe. Ahora, en un nuevo trabajo publicado en la revista científica Viruses, el equipo de investigación del LV demuestra que el Imiquimod también evita la multiplicación de dos coronavirus: el SARS-CoV-2 (responsable de la pandemia de 2020) y el coronavirus canino.
Como los ensayos con virus que significan algún riesgo para el ser humano se efectúan en laboratorios que cuentan con condiciones de bioseguridad estrictas, los estudios no pudieron completarse: “Pudimos demostrar la actividad antiviral del Imiquimod contra el SARS-CoV-2 en cultivos celulares. Pero, cuando quisimos estudiarlo en animales, el Instituto Malbrán, que es donde hay laboratorios seguros para hacer estos estudios, cerró por refacciones y nunca más pudimos acceder”, cuenta Carlos Bueno, investigador del CONICET. “Tuvimos algunas conversaciones para hacer los ensayos con animales en el INTA, pero ahora la situación allí está complicada”, comenta.
Si bien se sabe que el Imiquimod no actúa directamente sobre los virus sino que estimula la respuesta inmune de manera inespecífica (de ahí su acción antiviral de amplio espectro), todavía no se conoce su mecanismo de acción. “En este trabajo postulamos una posible vía de señalización”, acota el investigador.
Frente a una infección respiratoria, este antiviral se podría administrar sabiendo que va a ser efectivo frente a los tres principales virus respiratorios que afectan a los humanos.
En el paper, los autores señalan que “en los últimos 50 años, la Administración de Alimentos y Medicamentos de los Estados Unidos (FDA) ha aprobado solo 90 medicamentos antivirales, dirigidos únicamente a nueve enfermedades virales humanas. En el caso del SARS-CoV-2, las opciones terapéuticas incluyen nirmatrelvir (Paxlovid), remdesivir y molnupiravir potenciados con ritonavir. Estos antivirales se clasifican como agentes antivirales de acción directa, dado que están diseñados para atacar proteínas virales esenciales para la infección. Sin embargo, ya han surgido mutaciones que confieren resistencia a estos antivirales, y se han observado desafíos similares en otros virus”.
En este contexto, el trabajo que llevan a cabo en el LV buscando antivirales de amplio espectro cobra singular relevancia: “En el caso particular del Imiquimod, su importancia radica en que es una droga que ya está aprobada, en cuanto a su seguridad, para usarse en la clínica”, explica Bueno. “Por lo tanto, podría utilizarse como antiviral de amplio espectro frente a virus respiratorios”, añade, y finaliza: “Nosotros comprobamos esa actividad antiviral contra el sincicial respiratorio y el coronavirus, y ahora también estamos evaluando contra influenza, que son tres de los principales virus respiratorios. Entonces, frente a la infección respiratoria, este antiviral se podría administrar sabiendo que va a ser efectivo frente a estos tres virus, que son los principales virus respiratorios que afectan a los humanos”.
El trabajo publicado en Viruses forma parte de la tesis doctoral de Josefina Vicente, quien próximamente viajará a Canadá para probar Imiquimod –como spray nasal- en ratones infectados con el virus influenza.